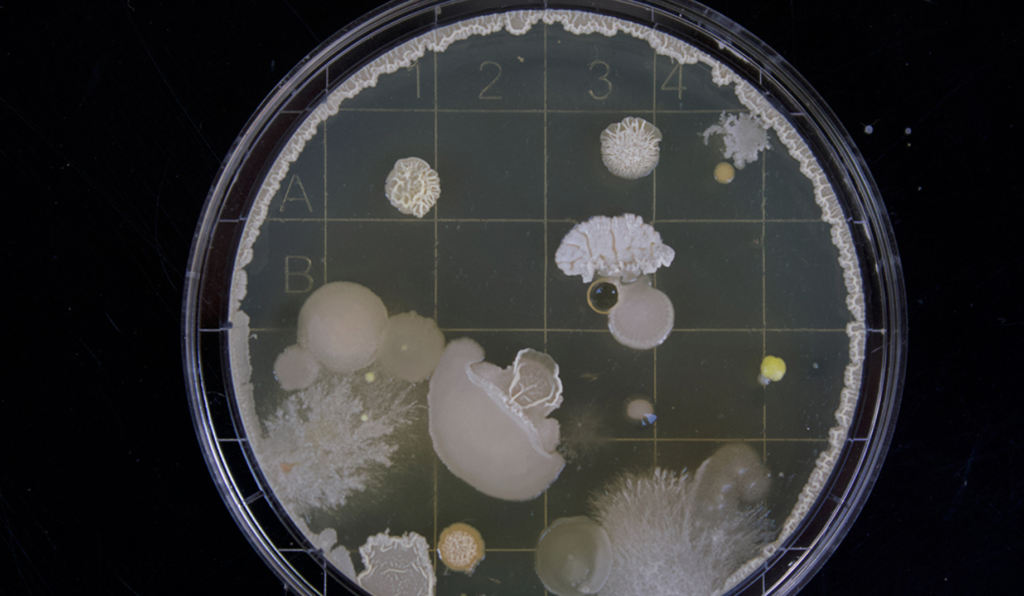

The sound of trickling water might seem harmless, even peaceful. But in the polar regions, this sound is a sinister warning of an event that could swallow up the arctic landscape.
What would happen to the climate? Why couldn’t you eat fish anymore? How much carbon is stored in the arctic?
We’ve really done it now. We ignored all the warnings. We ignored science. We thought we had more time. But now, the permafrost in the arctic is melting at an abrupt thaw, which means it’s happening fast.
As it melts, this formerly frozen layer of undecayed plant debris will release a massive amount of carbon into the atmosphere. And now, because of all that carbon, our time is up.

Permafrost covers an area about twice the size of the United States. It’s created when tundra plants, like grasses and mosses, die. Instead of decaying and releasing organic carbon, the plant matter is frozen into a layer of soil, trapping the carbon dioxide and methane that would have been released.
If this important layer in the arctic disintegrates, it would be catastrophic. As permafrost melts, the ice buried beneath the soil also melts. The draining water carries heat, spreading the dangerous thawing.
Tunnels and air pockets are created, and the ground sinks into the newly empty caverns below. Meltwater and rain fill the dents, expanding them into lakes. If hundreds of these happened at the same time, they could merge. This would create one giant mega slump where the Arctic landscape used to be.

The 13.1 million people who live in the arctic would have to flee immediately. Would they even be able to escape the expanding pit?
1,500 billion tons of carbon would be released into the atmosphere. That’s three times the amount stored in the planet’s forests. This is bad enough. But unfortunately, we are now in a positive climate feedback loop. The melting ice only increases the amount of heat the Earth’s surface absorbs, which then melts more ice. And this warms the planet.
Since the industrial revolution, humans have been releasing increasing amounts of carbon into the atmosphere. And the positive feedback loop amplifies that effect.
As the ice melts, the sea levels will rise, wiping out whole coastal cities. And even if you don’t live in the arctic, or on the coast, you’d still have a lot to worry about.

Climate change would come fast and fiercely. Droughts would dry up some places, while others would face an increase in precipitation.
Storms would rip through the cities that are left. And mercury from the melted permafrost would enter the oceans, wetlands, and food systems. You wouldn’t be able to eat fish anymore because it would have such high levels of this dangerous chemical.
And the arctic mega slump would never stop growing. More and more of Earth’s ground would become unstable, forcing people to flee South to higher ground. According to the 2018 Arctic Report Card, the Spanish flu, smallpox, and the plague could still be held in permafrost layers.
With the permafrost melted, these diseases would be released, and would spread rapidly among densely packed cities. Like I said in the beginning, if the permafrost melts, our time is up.
In reality, mega slumps don’t form overnight. But while you might not wake up to one new, giant mega slump, they are happening. The largest slump is Batagay in Siberia. It’s known as the ‘gateway to the underworld’. It measures more than 900 meters wide, and it’s continuing to expand.
And since the arctic’s temperatures have increased twice as fast as the global average, these slumps are more likely to happen. What can we do to stop more mega slumps from forming?
Our best option is to limit the amount of greenhouse gas released into the atmosphere while capturing carbon dioxide. If we fail to do this, then we’d better find a way to refreeze the arctic before it’s too late.

